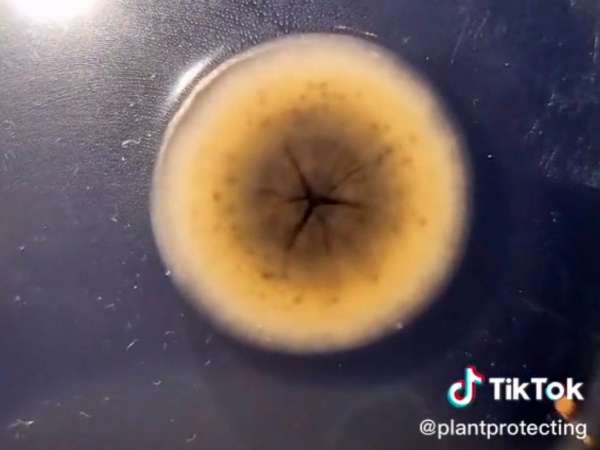

légkondicionáló
Már meg sem tudom számolni, hányszor sóhajtottam fel az idén, hogy „Csak tavaszodna már ránk!” Belátom, hogy az elmúlt aszályos időszak után ez az esős most aranyat ér, mégis várom már, hogy teraszokon kávézhassak méghozzá pokrócok nélkül, lehetőleg ingujjban.
A meleg beköszöntével újra reflektorfénybe kerülnek a klímák. Rettentő bosszantó, ha amikor tényleg kellene, nem indul a rendszer, ezt próbáljuk meg ma kiküszöbölni.
Előbb-utóbb itt lesz
A járművek légkondija nem csak a „30 fok plusszos” időben szükséges, hanem sok esetben már 24-25 foknál is be kell kapcsolni, mert az utastér a tűző napon átmelegedik, vagy menet közben dolgozik ránk az üvegház hatás. Persze ilyenkor még bőven ki lehet húzni leengedett ablakkal az utazást, de akkor meg bejön a por és a zaj.

Mercedes-Benz GLC - Zero layer technológiás klímamenü
Az Anyukám is érteni fogja rovat hasábjain sokszor foglalkoztunk már a klímák működésével, aki szeretné felfrissíteni az alapokat, az lapozzon vissza működési elveket és általános jó tanácsokat tartalmazó cikkünkhöz, haladóknak pedig az autóink hőháztartását tovább boncolgató írásunkat ajánljuk.
Kezünk az AC gombra téved
Akik nem ma kezdték, tudják, hogy a klímaberendezést nem csak nyáron lehet és kell használni. A hűtés mellett a légkondi ugyanis szárítja is a levegőt, így ősszel és télen is remek szolgálatot tud tenni, ha éppen belső párásodást tapasztalunk.
Amúgy jót tesz a berendezésnek, ha nem áll 6-8 hónapig, ugyanis a klímakompresszorok kenését a hűtőközben elegyített olaj végzi. Ha a kenés elmarad és a felületek kiszáradnak, akkor pedig beállhat a kompresszor és el sem indul, a megoldás sajnos ilyenkor a csere.
Ha nem indul
Gáz van, ha nincs gáz! A klímarendszer egy zárt kör. A rendszer fel van töltve az előírt mennyiségű hűtőközeggel, amit a köznyelv klímagáznak nevez. Ideális esetben a gáz nem tud kiszökni a körből, de csak idő kérdése, hogy a rendszer tömítetlenné váljon.

Egy ilyen rendszer számos helyen szivároghat. A klímának van külső és belső hőcserélője is. Mindkettő jó drága, de ha a belső hőcserélő szivárog, akkor az olyan szintű szétbontást igényel, amit a számlán az óradíjjal felszorozva látni hátborzongató. Ezen kívül csőkötéseknél is lehet szivárgás, ezek behatárolása szintén időigényes lehet.
A videón egy Suzuki belső hőcserélőjének cseréje látható kb. 4-szeres gyorsításban, valaki olyantól, aki láthatóan tudja, hova kell nyúlni.
Nem elég csak feltölteni
A tömítetlenségeket nem úgy kell elképzelni, mint a lyukas nylonzacskót, amiből fél perc alatt kifolyik a víz. Alattomos, sunyi kis réseken távozik a gáz, ráadásul lassan.
Nem mindegy az sem, hogy az előírt mennyiség mekkora hányada maradt még a rendszerben. Ha teljesen leürült, a klímarendszer tömítettségét ellenőrizni kell. Előfordulhat persze olyan kismértékű szivárgás, amit így sem lehet egyértelműen behatárolni, de az majd idővel biztosan jelentősebb lesz.
Intermezzo
Nem működő klíma esetén használtautó-vásárlásnál sem elégedhetünk meg egy olyan eladói válasszal, hogy „csak fel kell tölteni”. Ha ezt elfogadjuk és mégis valami nagyobb probléma van, akkor nagyon kellemetlen helyzetbe kerülünk és nem csak az utastér hőmérséklete miatt.
Az ékszíj is fontos
Jártamban-keltemben a kelleténél több autóban hallom visítani a hosszbordásszíjat. Ezzel a hibával elég sokáig el lehet járni, mármint fizikai értelemben, de tudni kell, hogy a légkondicionáló kompresszorát is ez a szíj hajtja meg a legtöbb autóban.

Ha időnként meg-megnyekken a szíj, vagy azt látjuk, hogy már elöregedett, repedezett, akkor időben cseréltessük ki a szíjat és a tönkrement görgőket, mert ez is okozhatja azt, hogy a klíma nem kapcsol be.
Lehet, hogy büdös is
A működő légkondi a hideg levegővel áthűti a rendszer csöveit és a belső hőcserélőt. Leállítás után a meleg levegő párája kicsapódik ezeken a felületeken, ami remek táptalaj az amúgy mindenhol jelenlévő gombák és baktériumok számára. A TikTok-on méltán népszerűvé vált Plantprotecting Rita nevű növényorvos le is tesztelte mi lesz a klímából érkező levegőben lévő kórokozókból 4 nap alatt a keltető csészében. Azt hiszem, ehhez nem kell kommentár.
Ezek a gombák a szolgáltatóknál többféle módban elérhető fertőtlenítő eljárásokkal jól kezelhetők, úgyhogy, ha indítás után rendszeresen büdöset fúj a klímánk, érdemes elvégeztetni egy ilyen beavatkozást. Aki inkább a megelőzésben hisz, annak pedig javasoljuk, hogy érkezés előtt néhány perccel kapcsolja ki a kompresszort, hogy a csövek és hűtők ne álló helyzetben száradjanak.
Időben kell cselekedni
Mint ahogyan lakásklímást sem lehet találni az első hőhullám közepén, úgy az autóklímásokhoz is sorszámot kell tépni ilyenkor. Érdemes hát letesztelni a rendszert és hiba esetén még időben „orvoshoz” fordulni, hogy mire itt lesz a kánikula, mi már a kellemesen hűs autóban utazhassunk.
További autós tartalmakért kövesse az Autószektor Facebook oldalát!